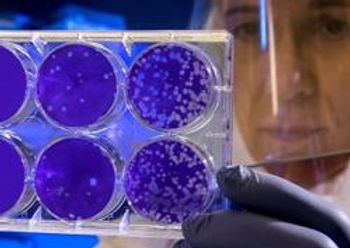

Booster shots are great, but the way back to our normal lives involves a multi-pronged approach to infection prevention.
Frank Diamond has been with Infection Control Today since November 2019. He has more than 30 years of experience working for magazines, newspapers, and television news.
Booster shots are great, but the way back to our normal lives involves a multi-pronged approach to infection prevention.

A CDC investigation shows 2.3 times the number of reinfections with natural immunity compared to breakthrough infections in those who are vaccinated.

The ruling was primarily made to benefit organ transplant patients but others with compromised immune systems, such as those battling cancer and HIV, would also be eligible for booster shots. They can be made available as early as tonight.

The FDA is expected to approve the move today, and the CDC could do the same tomorrow. The shots might be available by tomorrow night. Will those over 60 be next to be offered booster shots?

Kevin Kavanagh, MD: “COVID-19 is not just respiratory, it affects every organ of the body. This is a serious type of infection. And we need to be focusing on trying to keep this virus from spreading, plus protecting our young.”

The Nursing Home Improvement and Accountability Act of 2021 bolsters the standing of infection preventionists, but begs the question: Where’s the money going to come from?

As questions arise about vaccine efficacy and how effective they’ll be against the growing list of COVID-19 variants, the United States might have to rely more and more on another mitigation method: testing.

An infection prevention officer at the hospital along with key clinical personnel and administrators had to give the OK for the prototype mask to be manufactured.

G. Rumay Alexander, EdD, RN: “When experience shows up, it speaks and it speaks loudly. It usually shows up as a feeling, or a thought, or a belief, or a decision about who’s worthy of getting the best care, or the minimum amount.”

Data show how the lambda COVID-19 variant could possibly elude vaccines. One of the lead researchers of a new study calls lambda “a potential threat to the human society.”

Brace yourselves for a rough August in the United States, infection preventionists. But come September the country might see a sharp decline in Delta variant cases.

The Delta variant is burning through areas in the country where many people are unvaccinated and seems to be targeting younger Americans aged 50 and under and, says one ER physician, they’re “more intensive to care for.”

The CDC data seem to show just how vulnerable even vaccinated people are to the Delta variant.

Investigators in Chile conclude that the lambda COVID-19 variant is not only more infectious than standard SARS-CoV-2, but could also possibly shrug off vaccines. The first case in the United States has been spotted at Houston Methodist Hospital.

When the CDC updated masking recommendations earlier this week, the agency also updated COVID-19 testing recommendations.

In making the announcement, the VA noted that 4 of its employees have died in recent weeks, all of whom were unvaccinated. And 3 died as a direct result of the Delta variant.

Kevin Kavanagh, MD: “I am convinced this virus is about one or two iterations away from completely avoiding the vaccine. And remember, we have the lambda variant and the kappa variant which are sitting out there in the wings, waiting for immunity to drop and possibly cause another wave.”

Not nearly enough Americans are vaccinated to prevent COVID-19 from doing further damage. For some providers, dealing with patients who refuse to do what’s best for them can trigger compassion fatigue.

For the first time, according to the CDC, health care institutions in the United States have to grapple with a form of C. auris that’s resistant to all antibiotic and antifungal treatments.

Bug of the Month helps educate readers about existing and emerging pathogens of clinical importance in healthcare facilities today.

Despite the fact that the processes and layout of the laundry facility met industry standards, infection prevention teams found a significant number of mucormycosis-causing cultures.

The pandemic could leave in its wake a “tsunami” of chronic health conditions in younger people, including serious heart problems.

Ashish Mathur, PhD: “Today, there are no uniform industry standards to evaluate the efficacy of UVC devices. The onus is up to the infection preventionist to make sure and confirm that whatever claims have been made for the device are being substantiated by clinical evidence and third-party testing.”

Female health care workers under 30 years old are the most likely group to hesitate about getting the COVID-19 vaccine, a study concludes.

New COVID-19 cases in the country are at least 10% higher this week than they were last week. They’ve risen in 46 states, and in 31 states, new cases of SARS-CoV-2 are at least 50% higher.

Seven leading organizations representing health care professionals who routinely battle infections issued a joint statement today saying that COVID-19 vaccinations for health care workers should be mandatory.

That the COVID-19 vaccines operate under emergency use authorization has been cited as the main reason for the vaccine hesitancy that could lead to a Delta variant surge in the United States.

Heather Saunders MPH, RN, CIC: “I think [infection preventionists] really need to be aware of what the efforts are at their state health departments and how they can collaborate with those efforts. IPs need to also have their own surveillance systems in place. They need to know what they’re looking for.”

The Association for Professionals in Infection Control and Epidemiology received a grant under the CDC’s Project Firstline program to bolster IP educational opportunities.

The one-two punch of the Delta variant soaring, and COVID-19 vaccination rates stalling could put the United States in the crosshairs of another surge, medical experts fear.